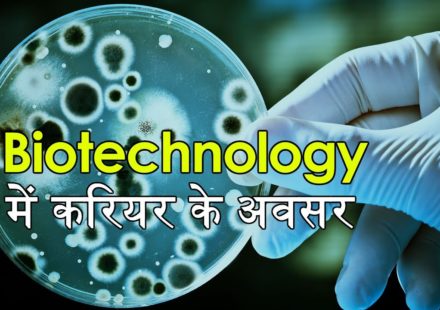
post-image

विज्ञान और तकनीक के क्षेत्र में भारत हर दिन नई ऊंचाइयों को छू रहा है। इसका एक उदाहरण...
Career
मातृभाषा होने के कारण हिंदी भाषा मुझे प्रिय रही है। इसके अलावा बचपन में परिवार में ऐसा माहौल था...
Career
Uncategorized
Posted on
आईआईएसईआर, पुणे में क्वांटम प्रौद्योगिकी में नया विज्ञान निष्णात कार्यक्रम
राष्ट्रीय क्वांटम मिशन के शुभारंभ के साथ, क्वांटम प्रौद्योगिकियों में कुशल कार्यबल की अत्यधिक आवश्यकता है। इस लक्ष्य को...
हम इंटरनेट युग में जी रहे हैं जहां पूरी दुनिया डैटा से घिरी हुई है। यह डैटा और कुछ...
Career
Uncategorized
Posted on
एसीएसआईआर भारत में डॉक्टरेट शिक्षा प्रदान करने वाला सबसे बड़ा संस्थान बनकर उभरा
केंद्रीय केंद्रीय विज्ञान एवं प्रौद्योगिकी मंत्री डॉ. जितेंद्र सिंह ने कहा है कि पूर्व के शिक्षित बेरोजगारों के लिए...
IIT Delhi launches M.Tech in Electric Mobility With the increasing air pollution and rocketing petrol and diesel prices, electric...
A career in biotechnology after 12th class. नमस्कार। न्यूज़ इन साइंस के करियर सेगमेंट में आपका स्वागत है। दोस्तों...
#AeronauticalEngineering #AerospaceEngineering #CareerOptions #After12th 12वी के बाद एरोनॉटिकल इंजीनियर । Aeronautical Engineer after 12th। News in Science In This...